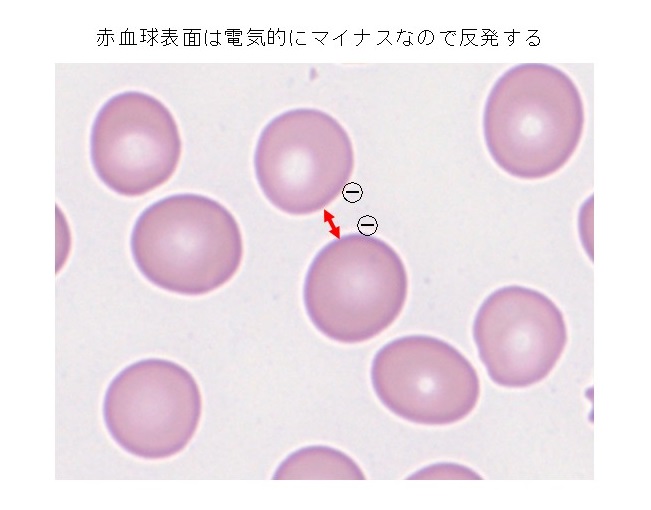

Please enjoy a piece of trivia.
基礎医学と小児病理について、実は疑問に思っていたかもしれないトリビアを小木曽先生が分かりやすく解説します。
不定期で連載していきますので、これからよろしくお願いします!
その15.赤血球と赤血球は反発する
最近よく耳にする「ドロドロ血」。いかにも不健康で不気味なイメージですが、血液がどうなればドロドロと呼ぶのか曖昧であまり科学的とはいえません。「サラサラ血」にしてもサラサラし過ぎて血が固まらないのであれば問題です。
赤血球そのものは、ドロドロ血であってもサラサラ血でも表面がマイナスに荷電しています。血液中には赤血球がぎっしりと含まれていても(血液体積の40%前後が赤血球)、マイナス同士が電気的に反発し合うのでそう簡単に赤血球同士がくっつくことはありません。健康な血液を顕微鏡でみれば赤血球はお互いに離れてバラバラになっています。 感染症などで炎症が起きると抗体(イムノグロブリン)とかフィブリノゲンのようなプラスに荷電するタンパク質が血中に増加してきます。そうしたタンパク質は赤血球表面のマイナス荷電を打ち消してしまうため、赤血球同士がくっつきやすくなります。この場合、赤血球は横1列に並ぶ傾向があって(連銭形成といいます)、イムノグロブリンが増加する多発性骨髄腫などの疾患を見つけるキッカケになることもあります。
その14.頸動脈はどこ?

憧れの人を目の前にすると、胸の鼓動が聞こえてしまうのではないかと思うほど胸がドキドキしてしまいます。このように心臓の拍動をそのまま感じられるような状態であれば脈拍数は簡単に数えられますが、一般的には外から動脈を触れることで脈拍数を計測することになります。
脈を触れる部位としては手首内側の親指側(橈骨動脈)が代表的です。他にも脈を触れられる部位は何カ所かあります。授業中に頬杖をついて居眠りをしていた人なら、耳の前で動脈(側頭動脈)の拍動を感じたことがあるのではないでしょうか。
脈を触れるということは心臓がちゃんと動いている証拠です。ところが心臓の動きが悪くなると脈を触れづらくなり、ついには頸動脈で確認できるのみとなります。頸動脈は体の外から脈を触れることができる大動脈に直結した太い動脈です。そのため心臓の拍動を最も間近に触れることができるのです。頸動脈は誰でも名前くらい知っています。ところが、「触ってみて」というと多くの人は正確に指し示すことができません。頸動脈を皮膚の上から触れられる場所は、図のように喉仏と胸鎖乳突筋(耳の後ろ付近から首の前を斜め下に通る筋肉)の間の部分です。イザというときのために知っておきましょう。ただし、無理に押すのは危険ですよ。
その13.男性は作られる?

男性の染色体は46,XY、女性の染色体は46,XX。生物学的な男女の別はX、Yという性染色体によって決まります。男性が持つY染色体にはSRY(精巣決定因子)遺伝子が存在していて、このSRYが胎児に働くと体内に精巣が形成されます。精巣はテストステロンなどの男性ホルモンを分泌し、その作用で男性型の性器が形成されます。一方、SRY遺伝子のない46,XXの胎児は精巣ができず、男性ホルモンが分泌されないために卵巣や子宮などを持つ女性型の体になります。
おわかりですか?胎児は男性ホルモンが働くと男性型の体になり、働かないと女性型の体になるのです。現実に46,XYであっても男性ホルモンが機能しなければ女性型の体になります。ただし、46,XXの胎児だって何もせずに女性になるのではありません。胎児期に女性化を促す特定の遺伝子が働いて女性になることが最近の研究で明らかにされています。
以上が性器の違いによる性です。脳の性、つまり男性か女性かの自己認識も胎児の脳に働く性ホルモンで決まるとされています。しかし、社会的な経験や環境の影響もあると考えられていて、この分野は今まさに研究が進められています。
その12.傷は治るけれど・・・

体が傷つくことは日常茶飯事ですが、私たちが生きている限り傷は治ります。もしも傷が治らないとしたら手術なんて危なくてできないし、注射した後は皮膚に穴があいたままです。傷が治る(創傷治癒)のは医学の基本中の基本であって、傷が治らなければ医学が成立しないどころか、そもそも生きていくことができません。
それでは傷はどうやって治っていくのでしょうか。皮膚が傷ついたときのことを考えてみましょう。まず、損傷した部分から出血したり組織液が出てきたりします。この中には線維芽細胞などの細胞に「増えろ」という指令(増殖因子)が含まれていて、傷の内部を線維芽細胞や線維芽細胞が作るコラーゲンなどで埋めていきます。損傷した空間がなくなっていくのと同時に、周りから表皮細胞が増殖してきて表面を覆ったら完成となります。これが創傷治癒の基本です。
傷ができたときに出る「増えろ」という指令については、かなりの部分が解明されています。それでは傷が治ったとき「止まれ」という指令はどうやって出るのでしょうか?いつまでも細胞が増え続けては大変なことになりますが、実はこちらの仕組みはまだよく分かっていません。
その11.抗生物質がウイルスに効かないのはなぜ?

抗生物質などの抗菌薬は、細菌が生存するために必要な物質を作れなくしたり(殺菌)、分裂できないようにして(静菌)、細菌感染症の治療に使われる薬品です。そのような抗菌薬が細菌に作用するためには、細菌の内部に取り込まれる必要があります。豆知識10に書いたように、感染した細菌は血液や体液の中で周囲の物質を栄養にして自力で生きています。細菌は自分の周りに抗菌薬が存在していると栄養と一緒に内部に取り込むことになり、最終的に死滅してしまうのです。
一方、ウイルスは細胞の外では単なる物質です。自分では増えることも、周りの物質を取り込むこともできません。あくまでも細胞の中でのみ自分を複製して増えることができます。血液や体液の中にどれほど高濃度に抗菌薬が存在したとしても、ただの物質であるウイルスには手も足も出ません。これがウイルス感染症に抗菌薬が効かない大きな理由です。
その10.ウイルスはバイ菌?

ここ数年のコロナ禍ですっかりお馴染みになったウイルスですが、細菌(バイ菌)とウイルスの違いがよくわからず、モヤモヤしている方も多いようです。病原ウイルスは人から人に広がっていくのだから、これは疑いなく生物であると思われるかもしれませんが、実はウイルスが生物なのか非生物なのか未だに結論が出ていません。
ウイルスが生物ではないとする根拠の一つが、自分だけで独立して増殖できないことです。細菌である乳酸菌の場合、外部の糖を乳酸に分解したときに発生するエネルギーで増殖します(牛乳の糖分が乳酸になったものがヨーグルト)。ところが、糖分のような外部の物質をエネルギー源にして増殖するウイルスはこの世に存在しません。ウイルスは他の生物の細胞の中で自分を複製させてもらっている存在であり、細胞の外では自力で増えることができないのです。
一方、ウイルスは遺伝子を持っているから生物であるという考え方もあります。他の生物の細胞に別の遺伝子を持ち込んで進化に影響することも知られています。
ウイルス、細菌、真菌(カビ)の説明は、また別の機会に詳しくお話する予定にしています。
その9.誤魔化せない細胞の老化

美魔女と呼ばれる女性ばかりでなく、外見から年齢を判断するのはなかなか難しいものです。年齢より若く見える人もいれば、反対に残念な方もいらっしゃいます。
人間の容姿のもとになる細胞の一つ一つはお化粧ができるわけではないので、細胞を見ればその人の生物学的な年齢を知ることができます。最も普通に培養される人間の細胞は皮膚の線維芽細胞です。線維芽細胞はコラーゲンを作り出す細胞で、ちょっとした知識と技術があれば誰でも容易に培養することができます。さて、この線維芽細胞、実際に培養してみると胎児、20代、40代、60代、80代で全く元気さが違っています。若年者の細胞ほど身が締まっていてどんどん増えてくれますが、80代ともなるとペタ~っとしてなかなか増えません。つまり、細胞の増え方を観察すればその人の生物学的な年齢がわかるのです。
しかし、誤魔化しのきかない生物学的年齢がわかるのは培養を始めた最初のうちだけです。たとえ胎児の細胞であっても、培養を続けて何度も分裂を繰り返していと80代の細胞のような姿になり、やがて分裂しなくなります。こうしてみると、老化とは細胞分裂を繰り返した結果なのかもしれません。
その8.腕と体のつながり方

腕と体をつなぐものは何か。当然のことながら、皮膚や筋肉は腕(上肢)を体(体幹)につないでいます。それでは骨はどうでしょう。肩の関節で腕と体がつながっている?いいえ、違います。肩の下にある骨は肋骨ですが、肩の骨と肋骨の間に関節はありません。
腕と体を結ぶ関節はただ一つ。鎖骨と胸の前面にある胸骨をつなぐ胸鎖関節だけです。鎖骨が腕の一部というのは意外かもしれませんが、胸鎖関節にメスを入れるだけで骨を切ることなく腕全体をはずすことができます。
肩の位置はそれなりに大きく動かすことができます。しかし、もし関節で肩と肋骨とつながっているなら、腕は下肢(股関節)と同じように肩を固定した運動しかできなくなるのです。
その7.骨の数

ある医療裁判で証人として呼ばれた医師が、証言の最中に相手方の弁護士(or 検事)から「人間の骨の数は何個ですか?」と突然質問されたそうです。これが都市伝説なのか、本当にあったことなのか不明ですが、即座に答えられる医師はまずいませんので、証言の信用性を落とすにはいい質問なのかもしれません。
医学部の教育は、解剖学などの基礎医学から始まります。解剖学の講義は骨学から始まることが一般的なので、人間の骨の数は最初のころに聞かされているはずです。ただし、ほとんどの学生は解剖学の試験が終わる頃にはそんな数字はすっかり忘れているので、あらかじめ想定していなければ裁判の証言台に立って緊張しているときに答えられるはずはありません。
人間の骨の数は206個です。もちろん若干の個人差はありますが、人間の体の基本構造は驚くほど同じです。ちなみに、犬の骨の数は319-321個、猫は244-245個、ニホンザルは189-203個で、特に尾の骨の数にばらつきが見られるようです。
その6.納豆菌と酵母

納豆菌は枯草菌と呼ばれる細菌の一種です。納豆を食べることは健康に良いとされていますが、増殖が早くて酒の醸造中に入り込むと材料がダメになってしまうため、酒蔵の敵とも言われています。
私が医学生時代の微生物学実習でカンジダ(酵母=イーストの一種)の培養をしたときのこと、我々のグループが培地に植え付けたカンジダ菌は他のグループより圧倒的に増殖が速く、通常は数日かかるところ翌日には菌でいっぱいになっていました。喜び勇んで指導教官に持っていくと、顕微鏡をのぞき込むなり「これは枯草菌だね。」のひと言。要するに、カンジダの培養を始めた日の朝、グループの誰かが納豆を食べてきたために手に付着した納豆菌が混入したのでした。
カンジダを含む酵母の仲間は真核生物という核を持つ生物です。細菌と比べて増殖が遅いために、両方一緒に培養すると大抵は細菌が圧勝します。納豆菌が学生実習の敵くらいなら大した被害はありませんが、酒蔵の敵は困りものです。
その5.胎盤は誰のもの?

妊娠中、お母さんは胎児に酸素や栄養を与えたり、老廃物を受け取って処理したりしています。このとき子宮の内側にあって胎児とお母さんを仲介している臓器が胎盤です。
そんな胎盤の役割は広く知られていますが、胎盤が胎児の一部なのか、お母さんの体の一部なのか、すぐに答えられる人は多くありません。実際に病院実習に来る医療系の学生(発生学を勉強していない)に質問してみると、6~7割が「お母さんの体の一部」、残り3~4割が「胎児の一部」と答えます。ちなみに出産経験のある女性に聞いてみると、お母さんの体の一部と答える人の割合はずっと高くなります。
実際はどちらなのかというと、母体の成分も多少は含まれていますが、胎盤は胎児の一部ということになります。胎盤は、胎児という樹木が子宮という大地に伸ばした根のようなものなのです。
その4.手洗いの原理

コロナ禍以降、手を洗う回数が増えました。しかも、“正しい”手洗いの方法がTV番組などでも紹介されていて、手順を図解したポスターを目にする機会もあるかと思います。
ところで、手というものは当然のことながら立体です。レンガと同じように、前面(手のひら側)、後面(背中側)、側面(指の先端を含めて)があります。しかも、複雑な形をしているので、手の表面全体をきちんと洗うためには前面、後面、側面を意識する必要があります。
どうですか?今まで教えられた手順通りであっても、漫然と手洗いをしていませんでしたか?正しい手洗いを知っている方も知らない方も、この機会に是非調べてみてください。手という立体の表面全体を洗っていることがわかるはずです。
その3.男と女の境界

赤ちゃんが生まれたら、外性器の見かけで男の子か女の子か判断して戸籍に登録します。これが社会的な性(戸籍上の性)です。お産が終わった後「男の子(女の子)でしたよ。」と伝える前に、遺伝子や染色体を検査しているわけではありません。あくまでも見かけによる性別の判定です。
普通はこれで全く十分なのですが、小児病理のような仕事をしていると、「あれ、どっち???」と困惑することがあります。胎児であれば性器の発達も未熟なのでなおさらです。外面をざっと観察して「男の子でしょう」と口にした後、よくよく調べてみると子宮や卵巣が見つかった、なんていう専門家として恥ずかしい思いをしたりします。
最近はLGBTQの問題が広く取り上げられていて、性の定義にも注目が集まっています。生物学的な性ですら確定が難しいこともあるのですから、男と女の間に明確が線を引くことは容易なことではありません。
その2.成長とは破壊と創造である

子どもが成長して大人になるとき、顔つきが多少変わることはあっても、基本的に同じ形のまま大きくなります。人間の体は細胞が集まってできているので、成長にともなって細胞の数は当然増えていきます。
それでは、細胞が増えることが成長なのでしょうか?たとえば骨の場合、骨の成分は骨芽細胞(造骨細胞)という細胞で作られます。子どもの骨も大人の骨と同じように内部が空洞のようになっていて、骨髄という血液を作る組織が入っています。しかし、骨芽細胞で骨の成分が作られるだけであれば、やがて骨は白くて硬い塊になって骨髄は消えてしまします。
つまり、同じ形のまま大きくなることはありません。骨の中には骨芽細胞の他に破骨細胞という骨を吸収する(壊す)細胞が含まれています。骨が成長するときは、破骨細胞が壊して広がったところを骨芽細胞が同じ形で少し大きく修復する作業を繰り返しています。成長とはただ細胞が増えることではなく、破壊と創造の結果なのです。
その1.血液を顕微鏡で見たら輸血したかどうかわかるの?

「この子は輸血しているね。」顕微鏡をのぞきながらつぶやくと、血液標本のプレパラートをもって相談に来たドクターが不思議そうな顔をすることがあります。
それもそのはず、彼は私にある重い疾患をかかえている新生児の標本ですと伝えただけで、輸血や治療のことはあとで話そうとしていたからです。実は、大人の場合は輸血したのかどうか、顕微鏡で血液を見ただけではわかりません。どんな顕微鏡を使っても、どれが誰の赤血球かなんてまず区別できないからです。
ところが、新生児の赤血球は大人より大きくて、ときには1.5倍くらいの容積があるので、輸血された大人の赤血球と新生児の血液は輸血されたかどうか大抵は一目で判断できます。